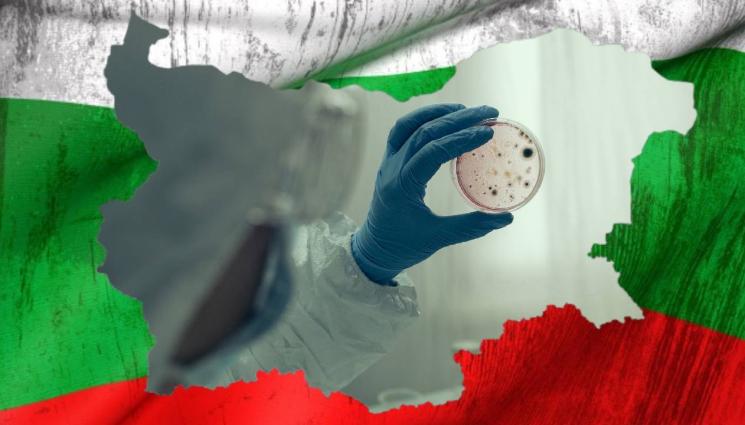
холера - ВНИМАНИЕ: Холера в България!

В нeсен случай на холера е регистриран в България. Става въпрос за 23-годишен индийски гражданин, живеещ у нас, който в периода между 13 август и 2 септември е бил в Ню Делхи, Индия.
За потвърдения случай докладва столичната Регионална здравна инспекция (СРЗИ). Пациентът заболява на 3-ти септември поради остра диария, без проява на други оплаквания. Извършено е лабораторно изследване, което впоследствие е потвърдено в Националната лаборатория по особено опасни бактериални инфекции към Националния център по заразни и паразитни болести.

Заболелият е изолиран в стая със самостоятелен санитарен възел в СБАЛ по паразитни и инфекциозни болести „Проф. Иван Киров“. Той е в добро общо състояние. Под задължителна карантина в същата болница е поставено и лице, с което болния съжителства, определено от СРЗИ като близък контактен. До момента той е без оплаквания, като има отрицателен резултат от изследване и му е проведена антибиотична профилактика.
В хода на проведеното епидемиологично проучване няма установени други контактни лица. Заболелият не е посещавал обществени места, включително ресторанти и др. В лечебното заведение e връчено предписание за спазване на стриктен противоепидемичен режим, засилена дезинфекция, носене на лични предпазни средства от персонала, с цел предотвратяване разпространението на заболяването.
Холерата е изключително заразно заболяване, предавано чрез поглъщане на замърсена храна или вода. Характеризира се с интоксикация, поражение на тънкото черво, гастроинтестинални прояви, дехидратация, тежко протичане и висока смъртност. Предаването на болестта на хора става чрез консумация на заразена вода, храна и чрез замърсени ръце и замърсени предмети.
До началото на ХІХ век холерата е разпространена главно в Индия, като река Ганг е основният източник на заразата. От 20-те години на ХІХ век болестта се разпространява и в други страни, като предизвиква пандемии с милиони жертви. В България холерата е била сериозен проблем шест пъти. Последната епидемия у нас е регистрирана в периода 1914 – 1918 г. Тогава заболяването е внесено през Румъния, като за посочения период са регистрирани 845 заразени и 146 починали. Последният случай от холера в страната е регистриран през 1921 г. и отново е бил внесен.
Благодарение на пречистването и хлорирането на питейната вода, по-късно заболяването практически е унищожено в Европа. Въпреки това броят на случаите на холера, докладвани на СЗО, продължава да бъде висок през последните няколко години, основно заради огнища в Африка и Южна Америка.
*Източник: NOVA